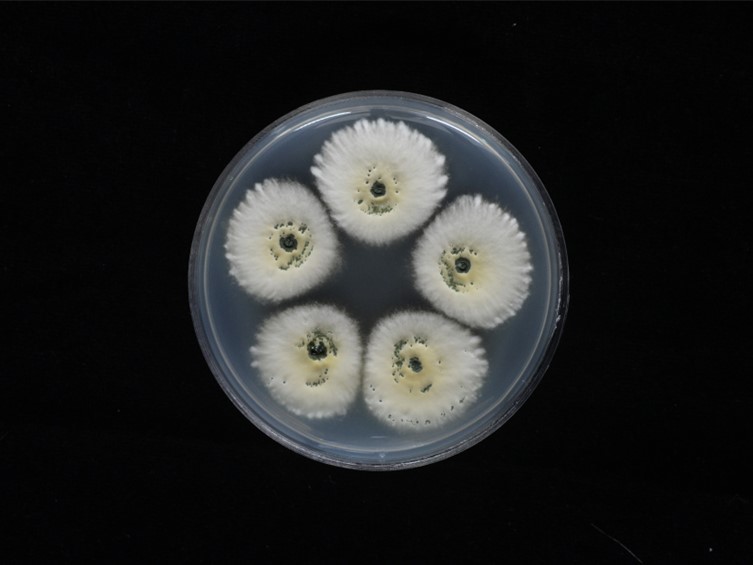

Holotype:
THAILAND, Chiang Mai Province, Huai Nam Dang National Park, 22 Sep. 2010, K. Tasanathai, P. Srikitikulchai, A. Khonsanit, holotype BBH 29715, ex-type living culture BCC 44270.
Habitat:
Underside of dicotyledonous leaves and bamboo leaves.
Host:
Leafhoppers (Hemiptera).
Description:
 Host covered with pale green mycelium and sporulating conidiophores.
Host covered with pale green mycelium and sporulating conidiophores.  Conidia
smooth-walled, pale green, cylindrical with rounded apices, 5-8 × 2-3 μm.
Conidia
smooth-walled, pale green, cylindrical with rounded apices, 5-8 × 2-3 μm.
Culture characteristics:
Colonies on PDA attaining a diam of 15 mm in 14 d, pale cream, floccose, irregular edge, velvety to woolly, pale yellow to dark green in the centre of colonies due to production of conidia. Sporulation starts at 14 d after inoculation, reverse uncoloured. Conidiophores terminating in branches, with 2–3 phialides per branch. Phialides cylindrical with semi-papillate apices, 5–10 × 2–3 μm. Conidia smooth-walled, dark green, cylindrical with rounded apices, 5–10 × 2–3 μm.
Colonies on PDA attaining a diam of 15 mm in 14 d, pale cream, floccose, irregular edge, velvety to woolly, pale yellow to dark green in the centre of colonies due to production of conidia. Sporulation starts at 14 d after inoculation, reverse uncoloured. Conidiophores terminating in branches, with 2–3 phialides per branch. Phialides cylindrical with semi-papillate apices, 5–10 × 2–3 μm. Conidia smooth-walled, dark green, cylindrical with rounded apices, 5–10 × 2–3 μm.
Reference:
Mongkolsamrit S, Khonsanit A, Thanakitpipattana D, et al. (2020). Revisiting Metarhizium and the description of new species from Thailand. Studies in Mycology 95: 171–251.
DOI: https://doi.org/10.1016/j.simyco.2020.04.001Species |
Strain |
Compound |
Pubchem CID |
Biological activity |
Reference |
|---|
|
Strain |
ITS | LSU | RPB1 | RPB2 | SSU | TEF1 |
|---|---|---|---|---|---|---|
| BCC 32190 | MN781899 | MN781855 | MN781757 | MN781954 | MN781710 | |
| BCC 44270 | MN781898 | MN781857 | MN781807 | MN781956 | MN781712 | |
| BCC 7672 | MN781901 | MN781856 | MN781758 | MN781806 | MN781955 | MN781711 |